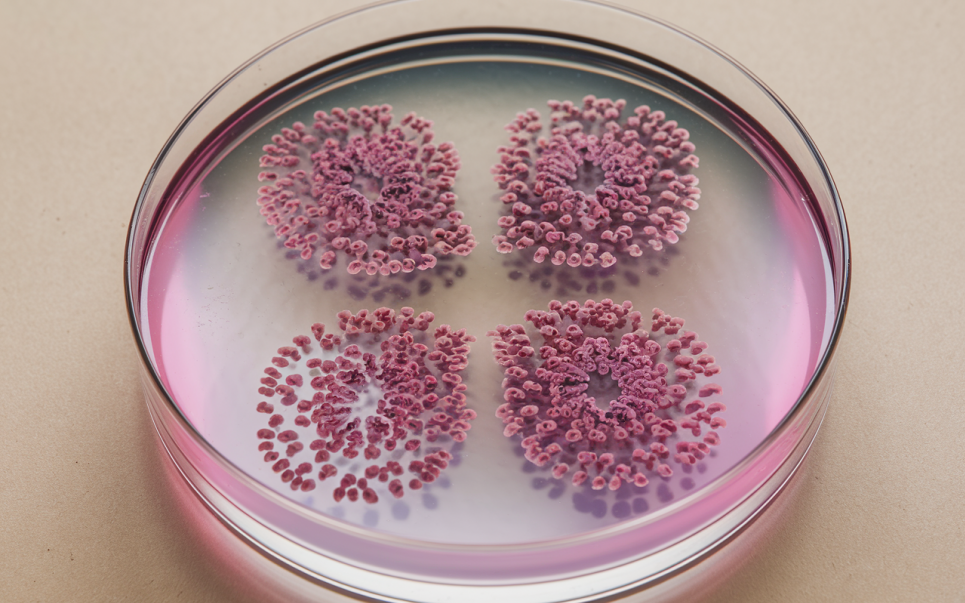
Дзеркальні клітини: синтетичне життя призведе до продовольчої кризи й масового вимирання — біологи Зображення згенеровано ШІ

Дзеркальні клітини: синтетичне життя призведе до продовольчої кризи й масового вимирання — біологи
Може знищити людство.
38 відомих біологів зробили тривожне попередження: через 10-20 років науковці зможуть створити мікроб, який може спричинити неконтрольовану пандемію, руйнівні втрати врожаю та крах цілих екосистем. Про це розповідає «Наша ніва».
Що таке дзеркальні клітини?
Уявіть, що ви дивитеся на себе в дзеркало — все перевернуто зліва направо. Щось подібне відбувається з дзеркальними клітинами, які є типом синтетичних клітин, які мають протилежну молекулярну структуру порівняно з природними клітинами.
Як пояснює Карл Циммер, у нашій ДНК кістяки складаються з правосторонніх молекул цукру, тоді як білки побудовані з лівосторонніх амінокислот. У дзеркальній клітині все буде навпаки: лівостороння ДНК та праві білки.
«Якби ми зробили дзеркальну клітину, ми створили б друге дерево життя», — говорить синтетичний біолог Кейт Адамала з Університету Міннесоти.
Це не жарт
12 грудня 38 відомих біологів опублікували тривожне попередження про те, що за кілька десятиліть наука зможе створити мікроорганізм із дзеркальними варіаціями ДНК і білків, здатний викликати пандемію, знищити врожай або порушити цілі екосистеми.
«Наслідки можуть бути глобально катастрофічними», — підкреслює Джек Шостак, лауреат Нобелівської премії з хімії. Він та його колеги наголошують, що «такий організм може спричинити надзвичайно шкідливі наслідки для довкілля, сільського господарства та добробуту людей».
Експерти з біозахисту відзначають, що дзеркальні клітини можуть подолати природні захисні механізми організму й імунну систему, і будь-які спроби стримати поширення інфекції можуть виявитися марними.
Ризики реальні
Хоча творці дзеркальних білків сподіваються використовувати їх у медицині (для створення ліків тривалої дії), розробка дзеркальної клітини може мати непередбачувані результати.
Наш імунітет розпізнає знайомі орієнтації молекул, але молекули дзеркальної клітини будуть для нього «невидимі».
Якщо дзеркальна клітина покине лабораторію — випадково чи в результаті спроби біологічної зброї — вона може обійти всі захисні механізми, на які покладаються наші тіла, культури й екосистеми.
Уявіть собі невидимого збудника, якого організм не може розпізнати та проти якого безсилі ліки. На відміну від звичайних бактерій і вірусів, які легко розкладаються в довкіллі, дзеркальні клітини можуть протистояти деградації, залишатися прихованими та розмножуватися.
Вони можуть повільно поширюватися серед людей, тварин і рослин, не викликаючи підозр, і з часом ця чужорідна біологія може поставити цілі екосистеми на межу зникнення. Від сільськогосподарських угідь до лісів — делікатний баланс природи може бути порушений, що призведе до глобальної продовольчої кризи та масового вимирання.
«Ми сказали собі: "Давайте більше так не робити"»
Зіткнувшись із серйозністю загрози, деякі науковці, як-от пані Адамала, вирішили відмовитися від роботи над дзеркальними клітинами: «Ми сказали собі: "Ми більше цього не робимо"».
Але питання, як змусити інших припинити це робити, залишається відкритим. У 2025 році заплановано проведення більших конференцій для обговорення законодавчих та етичних засобів контролю.
«Ризик створення дзеркальних бактерій не можна виправдати відносною користю», — резюмує проблему експерт із біозахисту Філіпа Ленцос.
Більше новин читайте на GreenPost.







